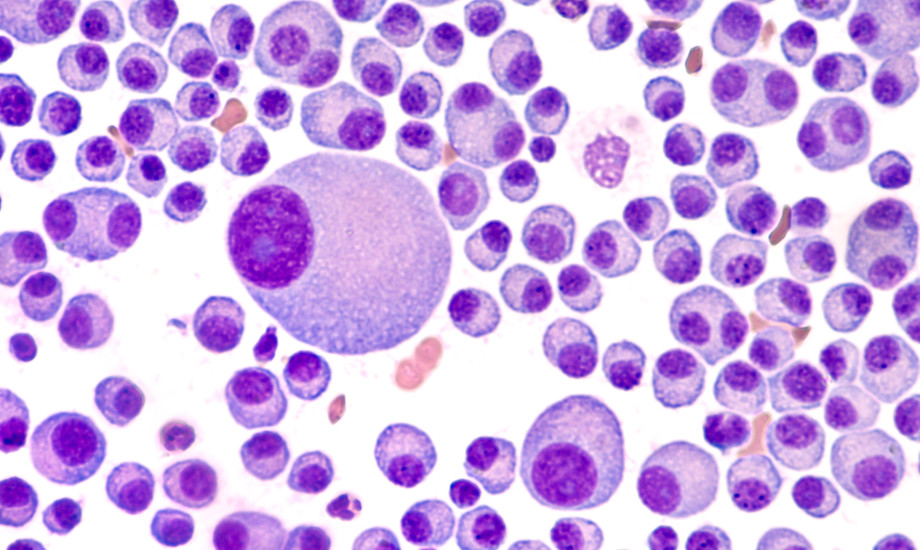

Isatuximab verlängert das progressionsfreie Überleben
Ein Antikörper gegen CD38, ein Protein auf der Oberfläche von Plasmazellen, verlängert das progressionsfreie Überleben beim Multiplen Myelom deutlich, hat eine Studie der Universität Heidelberg herausgefunden.